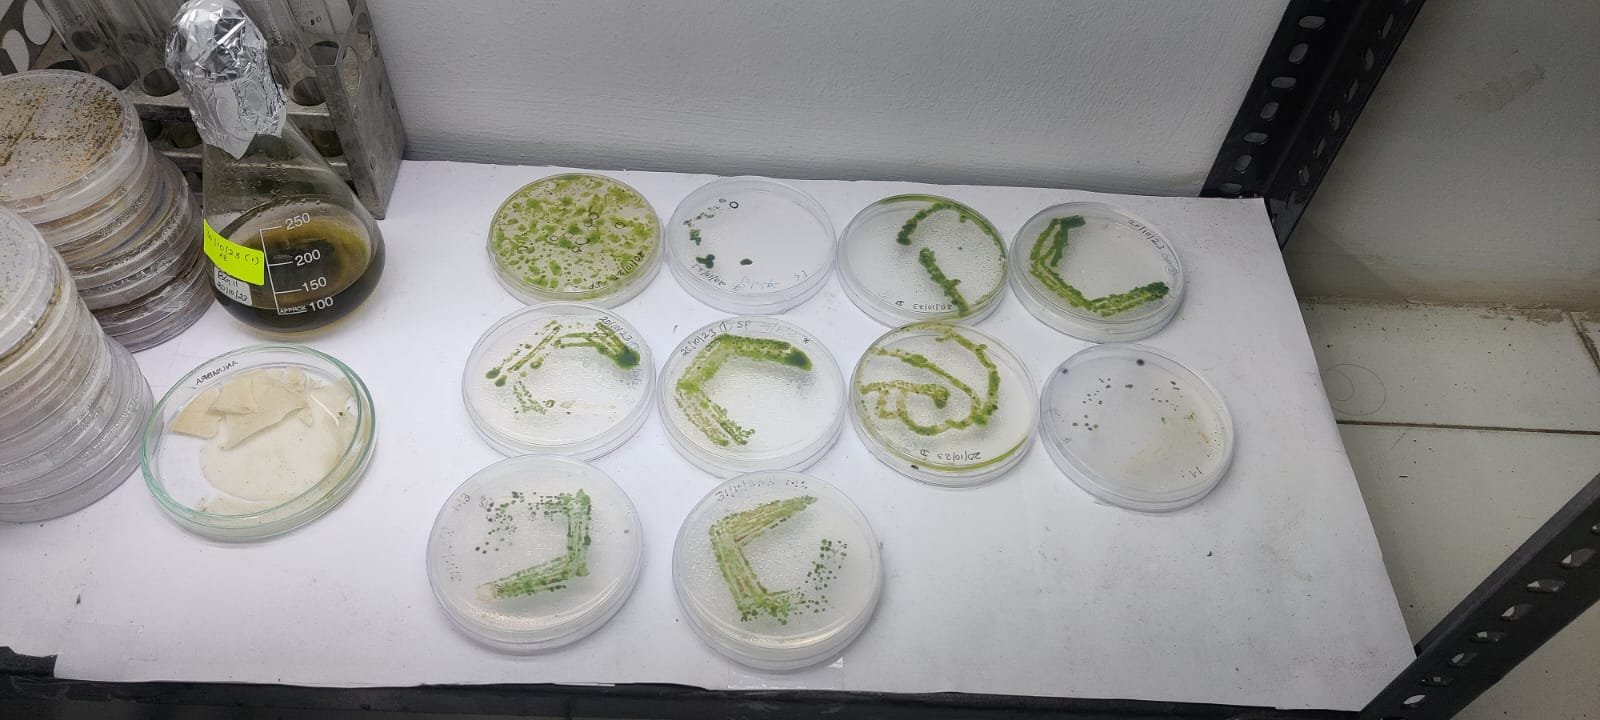

RESEARCH HIGHLIGHTS
Faculty members and students actively inculcate research activities with novel outcomes. We collaborative research with the clinical departments of our dental college and with other external colleges. Research studies are experimentally designed as per standards starting from fundamental research level to molecular level. All the research works are translated into publications in peer-reviewed indexed journals. The research works are presented in many conferences and seminars by students and faculty. In recent years, faculties and students have presented their novel research findings in IADR conferences in Korea, U.S, and the U.K and in national and regional conferences and have won many awards.
MAJOR FUNDED RESEARCH PROJECT
DST - SERB funded project
Title: Theragnostic strategy employing plasma genotyping and exosome profiling for early diagnosis of oral cancer
Amount: 45 Lakhs
Duration: 3 years (2020 - 2023)
Other Grants received by the faculty
International Conference on Infectious Diseases and Antimicrobial Resistance (ICiDAR) 2023
CSIR-HRD, April 2023
Dr Sankar Ganesh P - Rs 125,000
Awareness program on anti-microbial resistance (AMR) among stakeholders
Tamil Nadu State Council of Science and Technology, July 2023
Dr Raman M - Rs. 15,000
Biosafety and biorisk management consortium of excellence
Gryphon Scientific, June 2023
Dr Balakrishnan P - USD 3000
Good Clinical Laboratory practices (GCLP) workshop on international standards
DST-SERB, June 2023
Dr Balakrishnan P - Rs 150,000
International Conference on Infectious Diseases and Antimicrobial Resistance (ICiDAR) 2023
DST-SERB, April 2023
Dr Sankar Ganesh P - Rs 150,000
International Conference on Infectious Diseases and Antimicrobial Resistance (ICiDAR) 2023
DBT, India, April 2023
Dr Sankar Ganesh P - Rs 150,000
Development of a commercial chemical agent to control the flies
Sapience (Seed Grant), February 2023
Dr Raman M, Rs 30,000
Two panel lateral flow assay device for presumptive identification of oral cancer
Kairos Kinetic, September 2022
Dr Balakrishnan P, 4,12,000
Two panel lateral flow assay device for presumptive identification of oral cancer
Kairos Kinetic, September 2022
Dr Smiline Girija, 4,75,000
International Conference on Infectious Diseases and Advancements in Microbial Technology
DRDO, India, August 2022
Dr Sankar Ganesh P - Rs 50,000
Specialized Laboratories
Biofilm and Quorum Sensing Lab
Antimicrobial and anti-biofilm activities of active phytocompounds against bacterial pathogens
Attenuation of quorum sensing controlled virulence traits and biofilm inhibition by natural products
The crude solvent extraction procedures of the plant and herbs are assessed for their antimicrobial and anti-biofilm properties. We also facilitate the purification procedures and structure elucidation studies.
Antimicrobial activity (Plant, Essential oil, Synthetic compound)
Biofilm assay (Crystal Violet Staining assay
Virulence assay
Pyocyanin Pigment assay
Swarming motility assay
Las A assay
Las B assay
Rhamnolipid assay
Exopolysaccharide assay
Plant based quorum sensing inhibitors
Essential oil (Quorum sensing and biofilm assay)
Synthetic compound (Biofilm inhibitors)
C. elegans (Paralysis and Fast Killing assay)
Confocal imaging (Biofilm) study
Scanning Electron Microscopy (Biofilm) study
Florescent Microscopy biofilm analysis
Thin layer chromatography technique
Column chromatography technique
GC-MS analysis
Solvent extraction technique (plant extract)
Virology Cell Culture Laboratory
The Centre for Infectious Diseases hosts a dedicated laboratory for studying viruses, and viral pathogenesis that is the need of the hour. The research facility caters for the needs of research scholars and postgraduate students who have ventured into the field of Clinical Virology.
We provide the following services
Virus Cell Culture and Molecular Detection
Virus culture by Egg inoculation from clinical sample
Antiviral activity and determination of IC50 TCID50 and CC50
Dengue Real time PCR (serotype-specific)
Virus culture by Tissue Culture method from clinical sample
Chikungunya real time PCR
MTT cell cytotoxicity assay
Antiviral activity using Plaque reduction assay
Haemagglutination Inhibition assay
Bacteriophage screening, identification and sequencing
Molecular Detection of Antimicrobial Resistance Genes
Screening and Molecular Detection of ESBL and CRE
Analysis of LuxR gene expression
Special training/workshop/internship for students
Virus culture training – 3 days / 6 days
Virus culture and identification by real time PCR
Virus culture and molecular detection training (6 days)
Clinical Bacteriology Laboratory
Phycotechnology Lab
Skilled faculty members in designing and handling advanced molecular works
Clinical Genetics Lab
ONGOING FACULTY RESEARCH WORKS
Dr.A.S.Smiline Girija - Molecular and genetic studies on multi-drug resistant Acinetobacter baumannii [SRB approved project under SDC, SIMATS].
Dr.J.Vijayashree Priyadharsini - Association of vicK gene mutation (C470T) in Streptococcus mutans with Candidal carriage in bottle-fed infants [SRB approved project under SDC, SIMATS].
Dr. P. Sankar Ganesh - Antibiofilm and quorum sensing [SRB approved project under SDC, SIMATS].
Dr.N.P.Muralidharan - Association of non-anthrax Bacillus in UTI infections and diabetic foot ulcers and characterizing them for their virulence and toxicgenicity.
RESEARCH TRAINING
One PG student from the Department of Life Sciences, Central University of Tamilnadu, Thiruvarur is undergoing internship training in “Biofilm and Quorum sensing” under the supervision of Dr. P. Sankar Ganesh.
Three PG students from Dwaraka Doss Goverdhan Doss Vaishnav College, Chennai successfully completed their internship training in “Microbiology and Molecular Biology Protocols” from 27.06.2022 to 20.07.2022.
Two students from Mumbai Ms Manya Bhatia and Ms Sanjana Sridhar successfully completed their internship training in “Diagnostic Microbiology, Molecular Biology and Clinical Genetics” from 24.05.2022 to 03.06.2022.
Two students from Vellore Institute of Technology and Government Dental College successfully completed their training on “Molecular techniques” at the Clinical Genetics Lab, under the supervision of Dr.J.Vijayashree.
OVERALL PROJECT METRICS
Number of Postgraduate dissertations guided : >120
Number of Postgraduate short-term projects guided : > 230
Number of Undergraduate projects guided : > 716
Number of projects guided for other institutions : > 60
RESEARCH PRESENTATION AT THE INTERNATIONAL FORUM
Staff and students of the DEPARTMENT portray their research works at the International conferences
RESEARCH COLLABORATORS
We have signed the memorandum of understanding with the following research collaborators
ACADEMIC COLLABORATORS
Salem Microbes Pvt Ltd., is engaged in manufacturing and marketing of Microbial Cultures for the Aquaculture, Fishery, Poultry, Animal husbandry, and Ornamental Fish Industry. They are specialized in customizing Bio-remediation products for Environmental treatment for various types of industries.
Our academic collaborators are from the Central University of Tamil Nadu. The MoU was signed on the 20th of June 2019. Dr.E.M.Shankar and Dr.Meganathan Kannan, had delivered guest lectures during MicroSummit. They have also co-authored research papers by collaborating with our faculty member.
The center has a unique commitment to educating a broad spectrum of students—including undergraduate, post-graduate, and research scholars. Its pioneering curriculum is a model for many other Biotech institutions across the country and its practical training in Bioprocess engineering, Stem cell technology, Recombinant technology, protein engineering, molecular cell biology, Bioinformatics is highly valued.
VRR Institute of Biomedical Science is a higher education company affiliated to the University of Madras. The institution was established in the year 2009.
The University is making efforts to create new horizons in the arena of technical education and research. Curriculum innovation is given priority by the University to make the courses industry and research-oriented. The dedicated and qualified faculty members routinely preach and practice for outcome-based learning which leads towards an excellent academic career for the betterment of the students.
VEE laboratory Pvt Ltd, is the manufacturer of pharmaceutical medicines placed in Thanjavur, Tamil Nadu. The MoU was signed on the 12th of May 2021. The industrial collaboration will aid us in gaining access to pharmaceutical compounds which can be used for research purposes.
VRRX therapeutics Pvt Ltd, is a private limited company based in Chennai, India. The company is registered at Registrar of Companies, Chennai (RoC-Chennai), and is classified as a Non-govt company. They are a reliable organization engaged in providing a qualitative range of industrial products. They are also one of the leading companies of this highly commendable range of products.
ONEOMICS Pvt Ltd, has a team of highly qualified specialists with detailed knowledge of Genomics. There are experienced researchers and specialists in Human and Non-human genomics and next-generation sequencing technologies, who are passionate about leveraging the power of technology to advance health and quality of life.
Lingam Microbiological Laboratory (LML®) was initiated in 2014 and now have a dedicated Manufacturing site with well established Research & Development Unit. LML® has four units such as manufacturing, consultancy, research and diagnostic aspects of microbiology. They serve as an effective and quality assured source for microbiological laboratory tools with special focus on antimicrobial susceptibility test devices.
Elango Genetics Pvt Ltd is a global Contract Research & Development Organization (CRDO) providing Genomics services to a broad spectrum of industries spanning Lifescience, Healthcare, Veterinary science, Agriculture, Microbial and environmental genetics. Elango Genetics has a state-of-the-art research facility located in Ponneri, a sub-urban region of Chennai. Elango Genetics partners with the biotechnology, pharmaceuticals, nutraceuticals, food & beverage and dairy industries, hospitals, diagnostic labs, academia, research institutes and individual researchers.